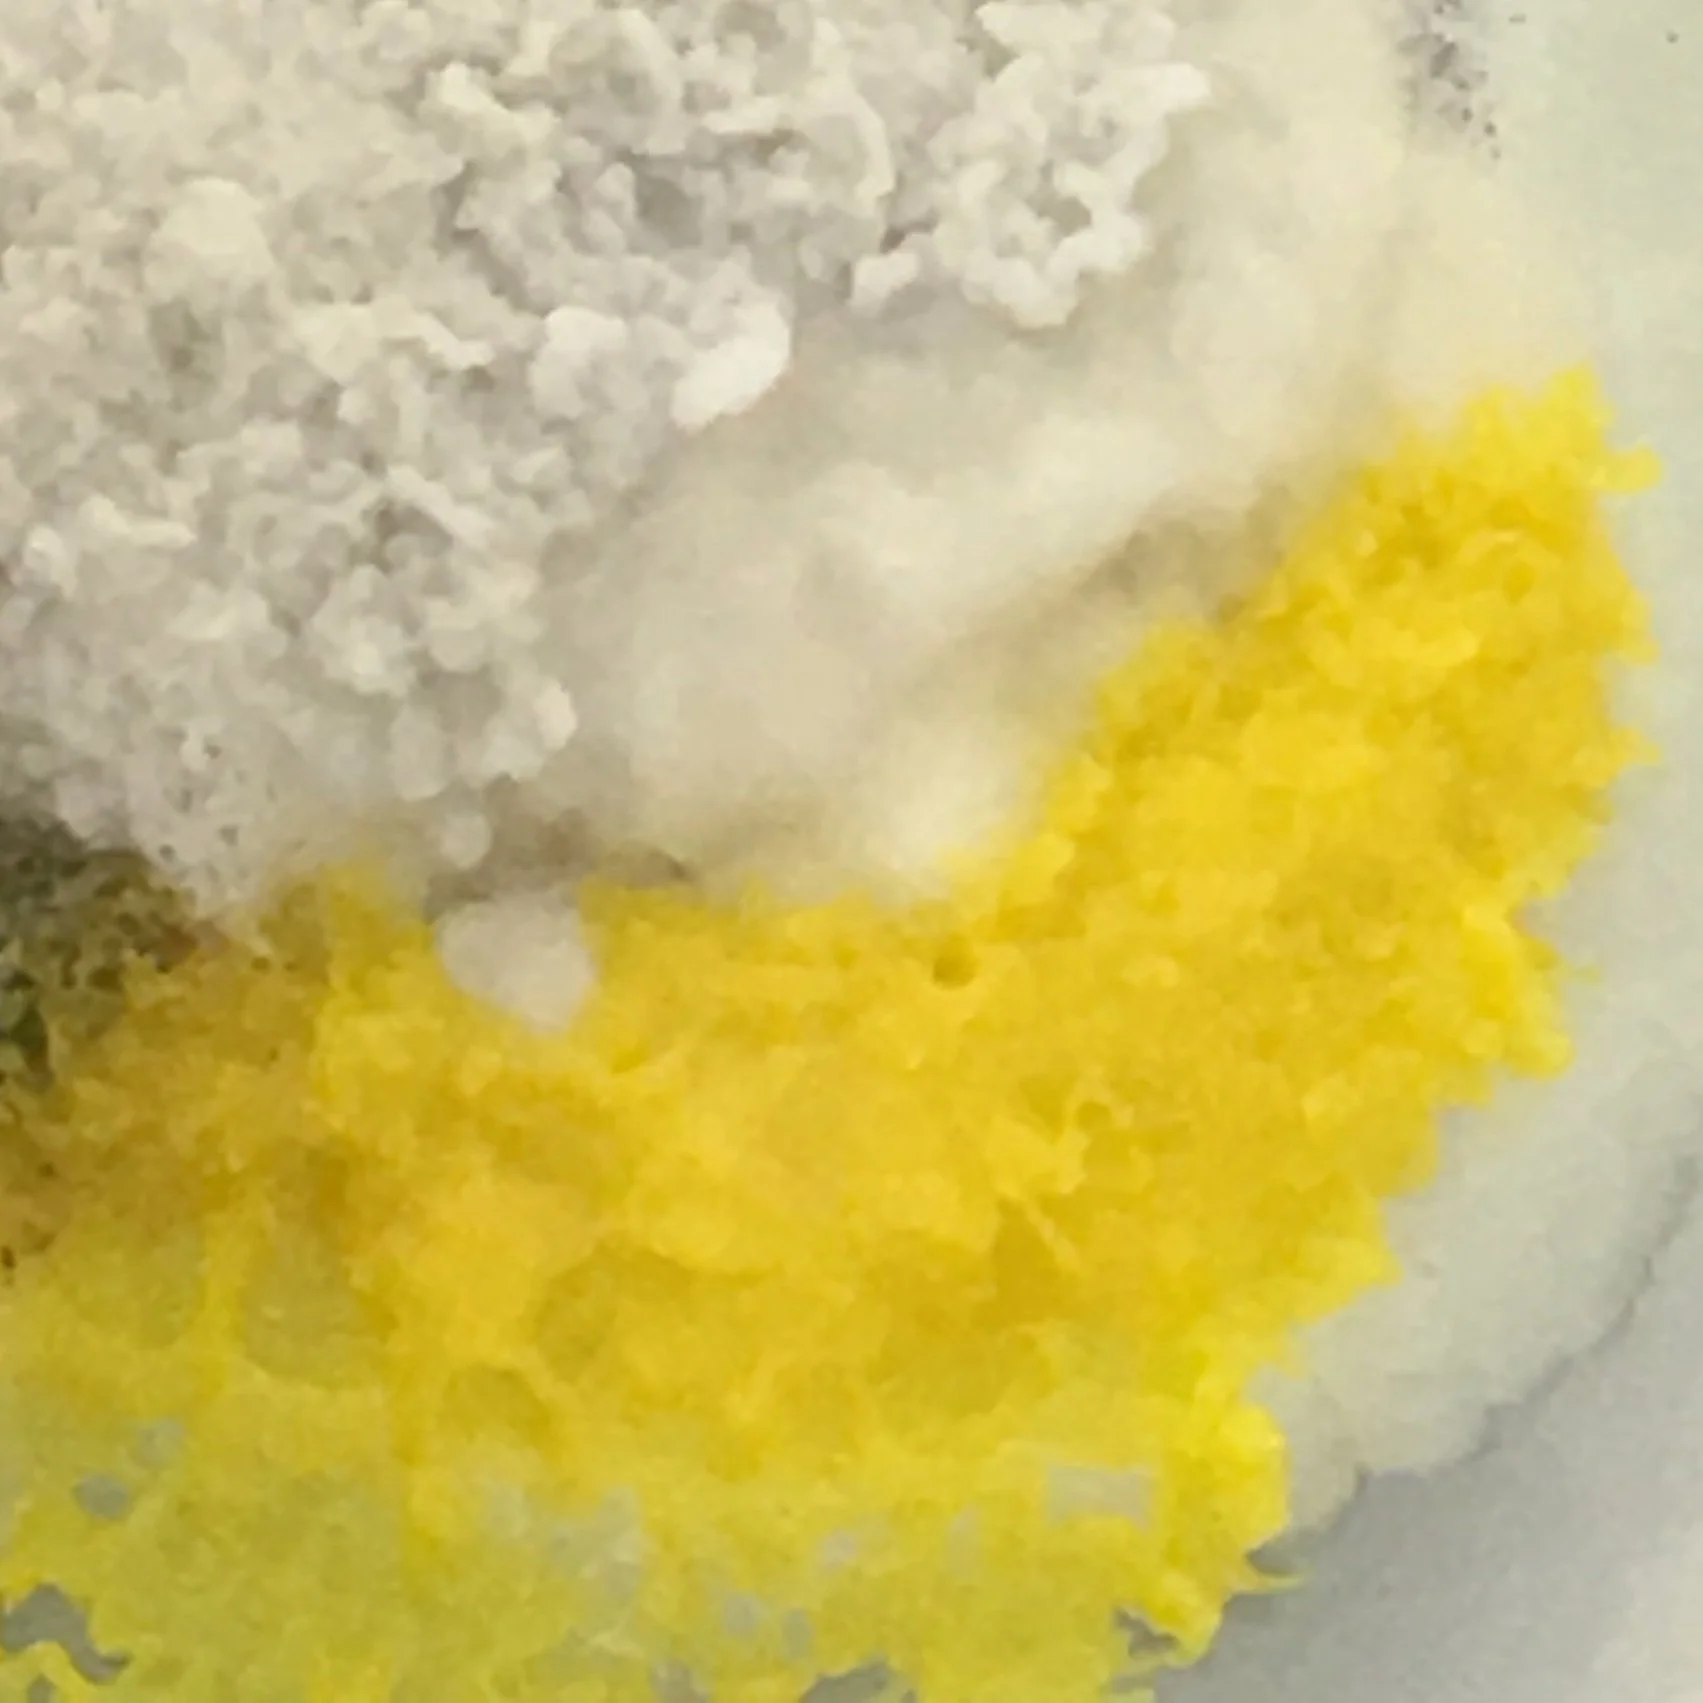
IMG_1360.jpg

This project explores the potential application of Physarum Polycephalum in the dye industry.
This process points to a more mindful approach to design which cares towards self, community and nature. A process that won’t promote the environment degradation but instead providing a more sustainable option in textiles.
Conventional dyeing industry pigments are mostly man-made from petrochemicals. This living organism is not harmful to humans and can be kept alive to grow indefinitely which at optimal conditions can expand up to 1 cm every hour.

The pigments produced by this genus of Slime Mould are of a vivid yellow colour but they can be turned also into other colours. This technique allows the production of textiles dyed with a broader colour palette and shades.